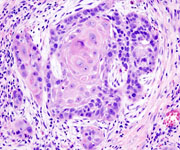
oncology_research

- Patients
back to top
- About UMSOD
Departments and Divisions- Dental Public Health
- Advanced Oral Sciences and Therapeutics
- Comprehensive Dentistry
- Microbial Pathogenesis
- Neural and Pain Sciences
- Oncology and Diagnostic Sciences
- Oral and Maxillofacial Surgery
- Dental Hygiene
- Orthodontics and Pediatric Dentistry
- Artificial Intelligence Research
- Biomaterials and Regenerative Dental Medicine
- Admissions
- Current Students
- Alumni

- University of Maryland School of Dentistry
- Research
- Research Programs
The University of Maryland, Baltimore is the founding campus of the University System of Maryland.
620 W. Lexington St., Baltimore, MD 21201 | 410-706-3100
© 2025-2026 University of Maryland, Baltimore. All rights reserved. - About UMSOD